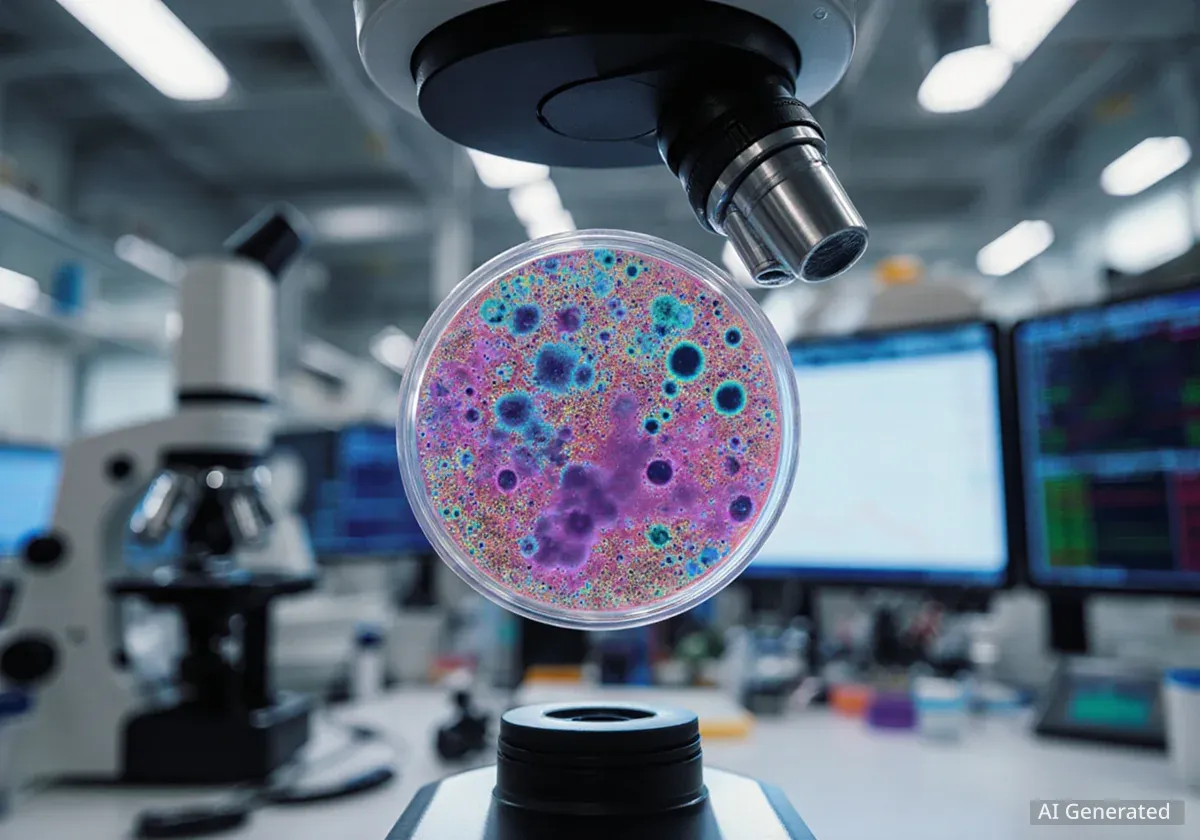

Life Could Thrive on Moons Without a Sun, Study Finds
New research suggests that moons orbiting sunless 'rogue' planets could maintain liquid water and potentially host life for billions of years through internal tidal heating.
Read MoreLatest Articles
Show MoreSpace Tech
Show More
NASA Begins Building Nuclear Drone for Saturn's Moon Titan
NASA has officially begun building its nuclear-powered drone, Dragonfly, which is scheduled to launch in 2028 to explore Saturn's largest moon, Titan.

Leo Gallagher
3/14/2026

ESA's Plato Satellite Endures Space Extremes in Crucial Test
The European Space Agency's Plato satellite is undergoing critical tests in a massive vacuum chamber, simulating the extreme hot and cold of space.

Leo Gallagher
3/13/2026

SpaceX Prepares for Another Starlink Satellite Launch
SpaceX is scheduled to launch 25 Starlink satellites from California on March 13, utilizing a Falcon 9 booster on its record 32nd flight.

Evelyn Reed
3/13/2026

NASA Astronauts to Conduct Spacewalks for ISS Power Upgrade
NASA astronauts Jessica Meir and Chris Williams are scheduled to conduct a spacewalk on March 18 to prepare the International Space Station for a major power system upgrade.

Evelyn Reed
3/13/2026

Voyager Backs Max Space for Expandable Moon Habitats
Voyager Technologies has made a multi-million-dollar investment in Max Space to accelerate the development of expandable habitats for future moon bases.

Evelyn Reed
3/12/2026
Space Science
Show More
Life Could Thrive on Moons Without a Sun, Study Finds
New research suggests that moons orbiting sunless 'rogue' planets could maintain liquid water and potentially host life for billions of years through internal tidal heating.

Leo Gallagher
3/16/2026

Japan's Underground Telescope Hunts for Cosmic Ghosts
Deep beneath a mountain in Japan, the upgraded Super-Kamiokande telescope is on the verge of detecting 'ghost particles' from stars that died billions of years ago.

Maya Singh
3/16/2026

Scientists Develop Method to See Inside Neutron Stars
Scientists have developed a new theoretical method to analyze the interior of neutron stars, which could confirm the existence of a state of matter from the Big Bang.

Leo Gallagher
3/15/2026

Spring Skies Offer Clear Views of Distant Galaxies
As spring arrives in the Northern Hemisphere, the night sky offers a clear window into deep space, revealing distant galaxies that are usually obscured by our own Milky Way.

Maya Singh
3/14/2026

Scientists Detect Record 128 Gravitational Waves in 9 Months
An international collaboration has detected 128 new gravitational waves in just nine months, more than all previous discoveries combined, revealing new cosmic extremes.

Maya Singh
3/11/2026
Space Defense
Show More
Space Force's Unseen Role in Mideast Conflict Revealed
Top U.S. military commanders confirm the Space Force is playing a critical, unseen role in Operation Epic Fury by degrading Iranian capabilities through electronic warfare.

Marcus Thompson
3/14/2026

Anduril Acquires ExoAnalytic to Bolster Space Surveillance
Defense tech company Anduril has acquired space surveillance firm ExoAnalytic Solutions, integrating its global network of 400 telescopes to bolster U.S. space security.

Marcus Thompson
3/11/2026

NASA's DART Mission Permanently Altered Asteroid System's Path
New data confirms NASA's DART mission in 2022 permanently altered the solar orbit of the entire Didymos-Dimorphos asteroid system, a historic first.

Leo Gallagher
3/10/2026

NASA's Asteroid Impact Had a Greater Effect Than Believed
New data from NASA's DART mission shows the 2022 asteroid impact did more than expected, altering the solar orbit of the entire Didymos-Dimorphos system.

Leo Gallagher
3/7/2026

India Engages Startups to Develop 'Bodyguard' Satellites
India's security agencies are partnering with private startups to develop 'bodyguard satellites' designed to protect the nation's critical space assets from orbital threats.

Marcus Thompson
3/5/2026
Space Policy
Show More
NASA Warns Florida Risks Space Lead Amid Funding Tensions
NASA's Kennedy Space Center director is warning Florida lawmakers that the state's leadership in space is at risk due to a lack of infrastructure funding.

Nathan Pierce
3/15/2026

Canada Plans Satellite Network for National Sovereignty
Canada is launching a major initiative to deploy hundreds of satellites, aiming to establish a sovereign network for national defense and reduce its reliance on U.S. systems.

Marcus Thompson
3/14/2026

Space Command Offers Bonuses for Alabama Relocation
U.S. Space Command is offering significant retention bonuses and moving expenses to its civilian workforce to encourage relocation from Colorado to Alabama.

Marcus Thompson
3/10/2026

China's Space Ambitions Threaten US Leadership Within 5 Years
A new report warns China's rapidly growing space program, fueled by massive investment, is on track to surpass U.S. dominance in the sector within five years.

Devin Sharma-Gupta-Patel
3/8/2026

Lawmakers Move to Extend ISS Lifespan to 2032
A U.S. Senate committee has proposed legislation to extend the International Space Station's operations until 2032, preventing its deorbit until a commercial replacement is ready.

Nathan Pierce
3/7/2026
Space Economy
Show More
Starlab Space Station Fully Books Payload Capacity
Starlab commercial space station has fully booked its payload capacity, securing early revenue and strong commercial demand, with German biotech Yuri reserving year-round access.

Evelyn Reed
3/11/2026

Private Companies Now Dominate Space Exploration
Private companies have taken the lead in space, conducting 70% of global launches in 2024. This commercial surge is driving the space economy toward a projected $1 trillion valuation by 2032.

Leo Gallagher
3/8/2026

Vast Secures $500 Million for Space Station Ambitions
Commercial space station developer Vast has secured $500 million in a new funding round to accelerate development of its Haven-1 private orbital outpost.

Evelyn Reed
3/6/2026

Japan's Space One Prepares Third Kairos Rocket Launch
Japanese startup Space One is preparing for a critical third launch attempt of its Kairos rocket, following two previous failures that ended in explosions.

Evelyn Reed
3/3/2026

London Prepares for Major European Space Industry Summit
London is preparing to host Space-Comm Expo, Europe's largest space industry event, on March 4-5, gathering over 5,400 global leaders to discuss technology, defense, and investment.

Leo Gallagher
2/17/2026
Browse by Category
Space Tech
354 articles
Space Science
275 articles
Space Defense
221 articles
Space Policy
209 articles
Space Economy
171 articles
Space
137 articles
Business
128 articles
Science
74 articles
Community
64 articles
Space Health
62 articles
Politics
44 articles
Tech
39 articles
Orbital Debris
37 articles
Sports
35 articles
Education
31 articles
Gear
27 articles
Health
26 articles
Space History
25 articles
Fitness
24 articles
Parenting
21 articles
Crime
20 articles
Gaming
19 articles
Defense Tech
17 articles
Real Estate
17 articles
Space Climate
15 articles
Environment
12 articles
Art
11 articles
Housing
11 articles
Fashion
10 articles
Space Culture
10 articles
Space Access
9 articles
Quantum
8 articles
TV
8 articles
Home Safety
7 articles
World
7 articles
Books
5 articles
Economy
4 articles
History
4 articles
Privacy
4 articles
Relationships
4 articles
Space Education
4 articles
Space Families
4 articles
Space Future
4 articles
Defense
3 articles
Drone Policy
3 articles
Food
3 articles
Movies
3 articles
Space Impact
3 articles
Technology
3 articles
Crypto
2 articles
Security
2 articles
Toys
2 articles
Weather
2 articles
Campus Politics
1 article
Health Tech
1 article